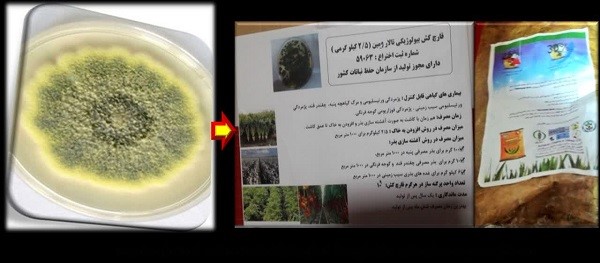

به همت عضو هیات علمی بخش تحقیقات بیماریهای گیاهی موسسه تحقیقات گیاهپزشکی کشور
روزهای انتقال یافته های تحقیقاتی برگزار شد
به گزارش روابط عمومی موسسه، دوره های آموزشی انتقال یافته های تحقیقاتی با عنوان « بیماری پژمردگی فوزاریومی گوجه فرنگی و روش های مدیریت بیماری با تاکید بر روش کنترل بیولوژیک» و «به کارگیری فرمولاسیون های بیولوژیک جدید برای مدیریت بیماری های مهم قارچی خاکزاد در محصولات گلخانه ای شامل گوجه فرنگی و خیار گلخانه ای» با تدریس لاله نراقی عصو هیات علمی بیماریهای گیاهی موسسه تحقیقات گیاهپزشکی کشور به ترتیب در مدیریت جهاد کشاورزی بخش جواد آباد در شهرستان ورامین و مرکز تحقیقات کشاورزی و منابع طبیعی استان تهران با حضور کارشناسان، مروجان و کشاورزان برگزار گردید.
نراقی در این برنامه آموزشی به شرح بیماری پژمردگی فوزاریومی گوجه فرنگی و ذکر علائم آن برای. همچنین در بحث مدیریت بیماری ، روش های شیمیایی، غیر شیمیایی و روش های به زراعی پرداخت
عضو هیات علمی موسسه در بخش روش های غیر شیمیایی نسبت به توضیح یافته های جدید به دست آمده در خصوص روش های کنترل بیولوژیک شامل به کارگیری چندین فرمولاسیون جدید به دست آمده از عامل قارچی مهارگر Talaromyces flavus اقدام کرد، همچنین وی در این دوره آموزشی دوم، یافته های جدید به دست آمده از پروژه های تحقیقاتی خاتمه یافته را شرح داد. عضو هیات علمی موسسه همچنین در این برنامه، روش ساخت فرمولاسیون های جدید از قارچ تالارومایسس فلیووس شامل میکروکپسول پودر، میکروکپسول سوسپانسیون و فرمولاسیون مایع و همچنین نحوه مصرف و روش مصرف آن ها را برای حاضرین بیان نمود.